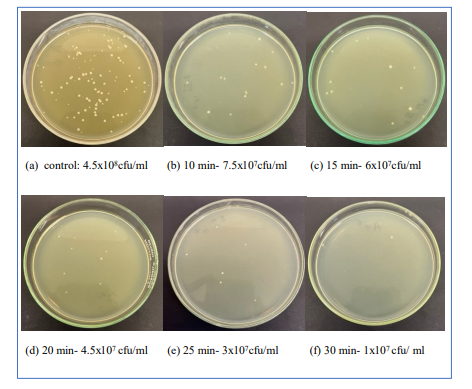

Research Article - (2025) Volume 9, Issue 2
Blue-Light Disinfection of Removable Dental Prostheses and Appliances: Mitigating the Limitations of Existing Reagents and Techniques
2Institute of Sciences, Department of Botany, Banaras Hindu University, Varanasi, 221005, India
#Equally contribution
Received Date: Aug 05, 2025 / Accepted Date: Sep 12, 2025 / Published Date: Sep 19, 2025
Copyright: ©©2025 Gopal Nath, et al. This is an open-access article distributed under the terms of the Creative Commons Attribution License, which permits unrestricted use, distribution, and reproduction in any medium, provided the original author and source are credited.
Citation: Shukla, A., Seyyadali, A., Rastogi, S., Nath, G. (2025). Blue-Light Disinfection of Removable Dental Prostheses and Appliances: Mitigating the Limitations of Existing Reagents and Techniques. J Oral Dent Health, 9(2), 01-11.
Abstract
Biofilms on removable dental prostheses create reservoirs for opportunistic pathogens, increasing the risk of localized and systemic infections. Effective, biocompatible disinfection strategies are essential to maintain oral health and prosthesis integrity. This study evaluated the antimicrobial efficacy of 450 nanometer blue-light phototherapy against Veillonella parvula, an early colonizer and bridging species in oral biofilms, and assessed its safety on human peripheral blood mononuclear cells. Biofilms were developed on polystyrene microtiter plates and coverslips, while planktonic cultures were prepared from the same inoculum. Samples were exposed to blue light for 10, 15, 20, 25, and 30 minutes. Biofilm biomass was quantified using crystal violet staining, planktonic viability was assessed by colony-forming unit enumeration, and cell cytocompatibility was evaluated through trypan blue staining and cytokine quantification by enzyme-linked immunosorbent assay.
Blue-light phototherapy induced a time-dependent reduction in biofilm biomass, with optical density decreasing from 1.60 ± 0.23 in controls to 0.34 ± 0.07 after 30 minutes, corresponding to approximately 79 percent reduction. Planktonic V. parvula showed fluence-dependent killing, with lethal dose values of 57.9 and 134.2 joules per square centimeter for 37 percent and 90 percent inactivation, respectively. Microscopic analysis confirmed structural disruption of biofilms at prolonged exposure. Human peripheral blood mononuclear cells maintained normal morphology, viability, and proliferation, and displayed no measurable cytokine response.
These findings demonstrate that blue-light phototherapy selectively and effectively targets Veillonella parvula in both biofilm and planktonic states without harming host immune cells. The approach relies on reactive oxygen species generated by endogenous bacterial chromophores, eliminating the need for chemical photosensitizers. Thirty minutes of 450 nanometer exposure represents an optimized therapeutic window, providing a safe, non-chemical, and reproducible strategy for disinfecting removable dental prostheses.
Keywords
Blue light, phototherapy, Biofilm, Veillonella parvula, Dental prostheses, Antimicrobial, Cytocompatibility
Introduction
Oral pathologies represent a significant global health burden [1], contributing to functional impairment and reduced quality of life. With the continuous evolution of scientific research, technological innovation, and advancements in biomaterials, contemporary dentistry increasingly integrates removable dentalprostheses as indispensable therapeutic modalities for managing a broad spectrum of oral pathologies. The maintenance of stringent hygiene standards for these prosthetic devices is critical, as inadequate decontamination facilitates their transformation into reservoirs for opportunistic and pathogenic microorganisms [2,3]. Such microbial colonization promotes biofilm formation, elevates the risk of localized and systemic infections, and ultimately undermines the efficacy and longevity of dental interventions. Accordingly, the effective decontamination of removable dental appliances constitutes a cornerstone of comprehensive oral healthcare, playing a pivotal role in mitigating biofilm-associated diseases while preserving the structural and functional integrity of the prostheses. Ensuring microbiological safety through evidence-based disinfection protocols is thus essential not only for prosthesis durability but also for safeguarding patient health and well-being [4].
While a range of chemical disinfectants including chlorhexidine gluconate, sodium hypochlorite, isopropyl alcohol, household bleach, soap, vinegar and glutaraldehyde demonstrate broad-spectrum antimicrobial activity, their clinical application is often limited by adverse effects such as mucosal cytotoxicity, discoloration of prosthetic materials, degradation of prosthesis surfaces, unfavorable organoleptic properties, and chemical incompatibilities with commonly utilized acrylic resins and metallic components [5-7]. Similarly, physical decontamination methods such as manual brushing, ultrasonic agitation and microwave irradiation, although effective in disrupting biofilms, are constrained by limited compatibility with certain prosthetic substrates and the potential to compromise material integrity [8].
In light of the limitations of chemical and physical disinfectants, there is a pressing need for alternative strategies that combine robust antimicrobial efficacy with biocompatibility, material preservation, and patient acceptability. Phototherapy has gained attention in medical and dental applications as a non-chemical method for sterilization and disinfection, offering the advantage of leaving no harmful residues [9].
Given the complexity of the oral microbiome, comprising over 700 microbial taxa, this study adopts a reductionist approach by selecting Veillonella parvula as a representative model organism. V. parvula is a Gram-negative anaerobe and a prominent early colonizer of oral biofilms, functioning as a bridging species that promotes multispecies community maturation [10,11]. Its metabolic reliance on lactate from primary colonizers and ecological role in facilitating late colonizers underscore its clinical relevance in prosthesis-associated infections.
Building on this premise, the present investigation systematically evaluates the antimicrobial efficacy of blue-light phototherapy against both planktonic and biofilm forms of V. parvula, while simultaneously assessing its cytotoxic potential on human peripheral blood mononuclear cells (PBMCs). This dual focus ensures that blue-light treatment parameters can be optimized not only for disinfection efficacy but also for clinical safety in the context ofremovable dental prostheses and appliances.
Materials and Methods
Biofilm Formation Assay
Biofilm formation by Veillonella parvula was standardized using a microtiter plate-based quantitative adherence assay, adapted from established protocols with modifications [12]. Briefly, an overnight culture of Veillonella parvulaobtained from Department of Microbiology, Institute of Medical Science, Banaras Hindu University was grown in Brain Heart Infusion (BHI) broth at 37 °C under anaerobic condition. The culture was adjusted to a turbidity equivalent to 1.0 McFarland standard (108CFU/ml). For biofilm induction, 20 µL of the standardized bacterial suspension was added to each well of sterile, flat-bottom 96-well tissue culture-treated polystyrene microtiter plate (Nunc™ MicroWell™ 96-Well, Thermo Fisher Scientific), containing 150 µL fresh BHI broth (HiMedia laboratories Pvt.Ltd,Mumbai India) and 40 µL of 1% sucrose solution . Negative control wells received only sterile broth and sucrose without bacterial inoculum.
Plates were incubated at 37 °C for 48 h to promote biofilm maturation. To minimize edge effects, peripheral wells were filled with sterile PBS and excluded from analysis. Each condition was tested in at least three technical replicates per experiment, and all assays were performed in three independent biological replicates.
In parallel, biofilm formation for microscopic observation was performed in sterile 6-well culture plates (Tarsons Pvt. Ltd. Kolkata, India) containing sterile coverslips placed at the bottom of each well. The same inoculum and medium composition were used, but for a volume of 3ml per well and plates were incubated under identical conditions without shaking.
This setup provided both a quantitative assessment of biofilm biomass in 96-well plates and qualitative microscopic visualization of biofilm architecture on coverslips.
Phototherapy Standardisation
Phototherapy experiments were conducted using a blue light-emitting diode (LED) system (TORPE-10W, 20 LED Blue B22) 900 lumens, with emission centered at 450 nm. The irradiance at the sample plane and corresponding fluence at 30 minutes 165.14 J/cm² were measured using a calibrated power meter to ensure consistent dosing across wells. The light source was positioned at a fixed distance of 11 cm above the plate, providing uniform illumination across the experimental wells. Temperature at the sample surface was monitored with a digital thermometer probe to rule out thermal artifacts during light exposure.
Two sets of phototherapy experiments were performed:
Phototherapy on Veillonella parvula Biofilms
Following 48 h of incubation, planktonic cultures were carefully aspirated from biofilm-containing wells of the 96-well plate and 6 well plate containing coverslip. The wells and coverslip were gently rinsed twice with sterile PBS to remove non-adherentcells. Residual moisture was retained to prevent desiccation of the biofilm or PBS was added in respective wells for Phototherapy. Both Plates and coverslip were then exposed to blue light for different durations for each section: 10, 15, 20, 25, and 30 minutes. Negative control wells (unexposed biofilms) were included on each plate.
After phototherapy, wells were gently rinsed with sterile PBS and air-dried at room temperature for 5-10 min. A volume of 200 µL sodium acetate solution (1% w/v) was added to each well and incubated for 15 min at room temperature for fixation. Wells were then washed three times with PBS, followed by staining with 0.3% (w/v) crystal violet in a dark chamber for 15 minutes. Excess dye was removed by three PBS washes, and the plates were air-dried briefly. Stain bound to biofilm was solubilized with 200 µL ethanol for 10 min at room temperature [13]. The optical density (OD) of the solubilized crystal violet was measured at 570 nm using a microplate reader (ThermoFischer Scientific, Multiscan FC). Controls (unexposed biofilms) were processed identically.
Coverslip biofilm after treatment is stained similarly as discussed above and viewed under microscope (Invitrogen, Evos XL Core) and compared with the control.
Phototherapy on Veillonella parvula Planktonic Cells
Planktonic cells removed from biofilm-containing wells were collected and transferred into fresh sterile 96-well microtiter plates and were immediately subjected to phototherapy under identical conditions as biofilms, with exposure durations of 10, 15, 20, 25, and 30 minutes. Unexposed wells containing planktonic cells served as negative controls. After treatment, bacterial survival was assessed by 10-fold serial dilution and plating on BHI plates, followed by colony-forming unit (CFU) enumeration after 24 h incubation at 37 °C.
Effect of Phototherapy on PBMC / Cytocompatability
Peripheral blood mononuclear cells (PBMCs) were isolated from fresh human peripheral blood collected in sodium heparin tubes from a healthy volunteer (colleague) after obtaining written informed consent. Isolation was performed by density gradient centrifugation using Ficoll-Paque (Lymphoprep™, Stemcell Technologies, Canada), as described [14]. Briefly, whole blood was diluted 1:2 with phosphate-buffered saline (PBS, pH 7.2) after plasma separation (centrifugation at 1800 rpm, 25 min, RT). Diluted blood was carefully layered over Ficoll and centrifuged at 1800 rpm for 20 min at RT in a swinging bucket rotor without brake. The mononuclear cell layer at the interphase was collected, transferred into fresh tubes, and washed three times with PBS containing 0.5% bovine serum albumin (BSA) at 300x g for 10 min each. Cells were finally resuspended in complete RPMI-1640 medium supplemented with 10% fetal bovine serum (FBS), 2 mM Lglutamine, and antibiotics (penicillin/streptomycin), and enumerated using a hemocytometer.
PBMCs were seeded into sterile 96-well culture plates at a density of 4.49 × 106 total cells/mL and respective wells were then exposedto blue light for different durations (10, 15, 20, 25, and 30 minutes), under the same irradiation parameters used for bacterial biofilm experiments. After irradiation the cells were incubated overnight at 37 °C in a humidified 5% CO2 incubator and observed under microscope. Negative controls consisted of PBMCs maintained under identical conditions without light exposure, and one for only media without PBMCs.
Viability of PBMCs was assessed using trypan blue staining followed by cell counting via hemocytometer [15].
The cytokine levels of IL-10 (anti-inflammatory) and TNF-α (pro-inflammatory) in the cell culture supernatants were quantified using enzyme-linked immunosorbent assay (ELISA) kits obtained from Thermo Fisher Scientific (Invitrogen, USA), following the manufacturer’s protocols. Briefly, samples and standards were added in duplicates to pre-coated 96-well plates specific for each cytokine and incubated at room temperature for the recommended duration. After washing to remove unbound substances, biotin-conjugated detection antibodies were added, followed by streptavidin-HRP and substrate solution. The optical density was measured at 450 nm using a microplate reader, and cytokine concentrations were determined by comparison to standard curves generated using recombinant cytokine standards provided in the kits. All reagents, incubation times, and washing steps adhered strictly to the manufacturer’s instructions to ensure accuracy and reproducibility.
Results
Establishment of Veillonella parvula Biofilm
Biofilm formation was confirmed after 48 h of incubation in 96-well polystyrene plates and on coverslips in 6-well plates. Quantitative crystal violet staining showed consistent biomass accumulation across replicates, with OD570 values of 1.60 ± 0.23 in untreated wells. Microscopic examination of coverslips revealed dense bacterial aggregates and extracellular matrix characteristic of mature biofilms.
Effect of Phototherapy on Veillonella parvula Biofilm
Crystal violet assay demonstrated that phototherapy significantly reduced biofilm biomass compared with untreated controls. The mean OD570 of the control group was 1.60 ± 0.23, whereas treated groups showed progressive reductions: 0.48 ± 0.12 (10 min), 0.48 ± 0.08 (15 min), 0.44 ± 0.12 (20 min), 0.42 ± 0.12 (25 min), and 0.34 ± 0.07 (30 min), corresponding to ~70–79% reduction in biofilm mass (Table 1).
One-way ANOVA (Figure 1) confirmed significant differences among groups (F = 317.81, p < 0.0001), supported by the Kruskal-Wallis test (H = 43.97, p < 0.001) (Figure 2). Tukey’s HSD posthoc analysis revealed that all treatment groups were significantly different from control (adjusted p < 0.001), and that the 30-min treatment produced a significantly greater reduction than 10 and 15min exposures (adjusted p < 0.05). No significant differences were observed among the intermediate durations (10-25 min) (Table 2).
These findings establish a consistent downward trend in OD with increasing exposure, with the most pronounced effect observed at30 min (Figure 3).

Figure 1: OD570 Distributions of Veillonella Parvula Biofilms After Blue Light Therapy at Different Exposure Times.

Figure 2: Kruskal-Wallis, Percentage reduction of Veillonella parvula biofilm biomass after blue light therapy at different exposure times.

Figure 3: Dose-Response Trend of Blue Light Therapy on Biofilm.
|
Condition |
Mean OD ± SD |
% Reduction from Control |
|
Control |
1.60 ± 0.23 |
0.00% |
|
10 min |
0.48 ± 0.12 |
69.8% |
|
15 min |
0.48 ± 0.08 |
69.5% |
|
20 min |
0.44 ± 0.12 |
72.5% |
|
25 min |
0.42 ± 0.12 |
75.5% |
|
30 min |
0.34 ± 0.07 |
78.5% |
Table 1: Biofilm ODâ??â??â?? ± SD and % Reduction of V. Parvula After Blue Light
|
Group 1 |
Group 2 |
Mean Diff |
p-value |
|
Control |
10 min |
1.13 |
<0.001 |
|
Control |
15 min |
1.15 |
<0.001 |
|
Control |
20 min |
1.30 |
<0.001 |
|
Control |
25 min |
1.22 |
<0.001 |
|
Control |
30 min |
1.41 |
<0.001 |
|
10 min |
15 min |
0.02 |
0.998 |
|
10 min |
20 min |
0.17 |
0.134 |
|
10 min |
25 min |
0.09 |
0.618 |
|
10 min |
30 min |
0.28 |
0.016 |
|
15 min |
20 min |
0.15 |
0.163 |
|
15 min |
25 min |
0.07 |
0.728 |
|
15 min |
30 min |
0.26 |
0.023 |
|
20 min |
25 min |
-0.08 |
0.588 |
|
20 min |
30 min |
0.11 |
0.308 |
|
25 min |
30 min |
0.19 |
0.103 |
Table 2: Tukey’s HSD Pairwise Comparison of Biofilm Od Values After Phototherapy
Microscopic examination of biofilms grown on coverslips (40x magnification) revealed a dense, uniform layer of adherent cells in the untreated control group. In contrast, phototherapy-treated groups exhibited visibly reduced biofilm density and disrupted architecture, with the 30 min exposure showing the most pronounced reduction (Figure 4).

Figure 4: Biofilm under microscope after treatment, compared with Control
Effect of Phototherapy on Planktonic Cells
Phototherapy significantly reduced planktonic Veillonella parvula counts compared to untreated control (4.5x108 CFU/mL). A progressive decline in viable cells was observed with increasing exposure time: 7.5x107 CFU/mL (10 min) to 1x107 CFU/mL (30 min). The greatest reduction was recorded in 30 minutes of treatment, consistent with biofilm biomass results. (Figure 5) When exposure times were converted to fluence values (55.05, 82.57, 110.09, 137.61, and 165.14 J·cm-² for 10, 15, 20, 25, and 30 min, respectively), a clear fluence-dependent killing effect was evident. Plotting the natural logarithm of the survival fraction. In N/N0 against fluence revealed a linear relationship (Figure 6). Regression analysis of the 10-30 min data points yielded an inactivation constant (IC) of -0.0172 J-¹·cm², with an intercept of -0.636 (R2 = 0.884, p = 0.017).
From this slope, the lethal dose values were derived as follows: • LD37: 57.9 J·cm-² (≈10.5 min) • LD90: 134.2 J·cm-² (≈24.4 min)
These results demonstrate that planktonic V. parvula is highly susceptible to blue-light exposure, exhibiting a pronounced dose-dependent inactivation, with substantial reductions achieved at fluences above 100 J·cm-².
Figure 5: Effect of phototherapy on Veillonella parvula planktonic Cells via CFU calculation

Figure 6: Blue-light inactivation of Veillonella parvula planktonic cells. Survival ln(N/N0) vs fluence
Effect of Phototherapy on PBMC / Cytocompatability
Phase-contrast microscopy demonstrated that PBMCs maintained normal morphology and exhibited proliferative growth across all exposure groups (10-30 min), comparable to the untreated control (Figure 7). Cells incubated at 37 °C in a humidified 5% CO2 atmosphere retained viability, confirming that the applied phototherapy parameters were cytocompatible. ELISA assays for IL-10 and TNF-α showed no measurable cytokine response following blue-light exposure compared with the control. Standard curves exhibited excellent fit (R2=0.9983) confirming assay reliability (Figure 8). However, all measured values remained at or below the lower detection limit of the standard range. IL-10 concentrations were undetectable (0.00 pg/ mL) from 0-20 min and only marginally detected at 30 min (0.67 pg/mL), while TNF-α values remained very low (2.37-4.14 pg/ mL) across all time points. These findings indicate that cytokine levels were below the standard curve range, and no significant cytokine response was induced under the tested conditions.
|
Conditions |
Before Phototherapy |
After Phototherapy (24hr incubation) |
|
Control(No light exposure) |
|
|
|
10 minutes exposure |
|
|
|
15 minutes exposure |
|
|
|
20 minutes exposure |
|
|
|
25 minutes exposure |
|
|
|
30 minutes exposure |
|
|
Figure 7: Phase Contrast Images of PBMCs Taken Before and After Blue Light Exposure, Followed By 24 Hours of Incubation.

Figure 8: (a) IL-10 ELISA standard with sample readings (b) TNF-alpha ELISA standard with samples.
Discussion
Veillonella parvula served as an appropriate model organism in this investigation due to its pivotal role in oral biofilm ecology and its frequent association with prosthetic surfaces. While largely considered a benign commensal, its capacity to act as an early colonizer and interact synergistically with streptococci enhances biofilm stability and resilience, thereby creating a foundation that permits subsequent colonization by more pathogenic species. Such ecological positioning highlights the importance of targeting V. parvula when developing disinfection strategies for removable dental prostheses, as effective elimination of early stabilizers may limit downstream biofilm maturation and associated clinical complications [11,16].
In this study, 450 nm blue light irradiation demonstrated significant disruptive effects on both planktonic and biofilm-associated V. parvula, reducing microbial biomass and viability in a timede-pendent manner, with maximum activity observed at 30 minutes of exposure. These findings corroborate prior evidence indicating that blue light induces photo-oxidative stress and disrupts micro-bial metabolism and biofilm integrity. Importantly, the absence of cytotoxic effects on human PBMCs suggests a favorable safety profile when compared to conventional disinfectants, which often pose risks of mucosal irritation or material degradation [5-7]. Col¬lectively, these results position blue light phototherapy as a prom¬ising, biocompatible alternative for the disinfection of removable dental prostheses, offering both antimicrobial efficacy and preser¬vation of prosthetic material integrity.
4.4. Mechanistic Basis A key advantage of blue light therapy is its multifactorial mode of action. Unlike conventional antibiotics that target specific molecular pathways, ROS-mediated damage affects multiple cellular components simultaneously, making it difficult for bacteria to mount stable resistance [18,19]. This may account for the consistent and reproducible reductions we observed across independent experiments. Moreover, the plateau in optical density reduction after shorter exposures (10-25 minutes), followed by a significant additional decline at 30 minutes, reflects the time-dependent kinetics of ROS accumulation, where sustained irradiation is necessary to achieve maximal oxidative stress and biofilm disruption [19,29].
Blue Light Efficacy Against Biofilms
Biofilm biomass quantification by crystal violet staining revealed a clear dose-response trend (Figure 6), with OD570 values progressively decreasing as the exposure time increased from 10 to 30 minutes. One-way ANOVA confirmed highly significant dif-ferences among treatment durations (p < 0.0001), while the Kruskal-Wallis test (p < 0.001) further validated the consistency of these findings under non-parametric assumptions. These strong p-values underscore the reliability of the statistical outcomes.
To further dissect the differences among groups, Tukey’s HSD post hoc test revealed that all treatment groups differed significantly from the untreated control (p < 0.001). Importantly, the 30minute treatment produced a significantly greater reduction in OD compared to the 10- and 15minute exposures (p < 0.05). Inter-mediate groups (10-25 minutes) did not significantly differ from one another, suggesting that biomass reduction reaches a plateau after initial exposure and that prolonged irradiation is required to push the biofilm into a state of maximal disruption. These results confirm that the treatments induced a statistically robust and biologically meaningful decrease in OD relative to control, with the most pronounced effect at 30 minutes.
Microscopic examination corroborated these findings. Control biofilms displayed dense aggregates embedded in extracellular matrix, while bluelight-treated biofilms showed progressive structural collapse. The 30-minute group demonstrated strikingly thinned and discontinuous structures, directly visualizing the statistical trends observed in OD reduction and providing morphological validation of biofilm disruption.
Effect on Planktonic Cells
A similar time-dependent decline was observed in planktonic V. parvula populations, with CFU counts dropping by nearly an order of magnitude after 10 minutes of exposure and reaching the lowest values at 30 minutes. This convergence of biofilm and planktonic results reinforces the bactericidal efficacy of blue light at prolonged exposure and demonstrates its dual impact on sessile and free-living bacterial forms.
Planktonic V. parvula displayed clear fluence-dependent susceptibility to blue light, with an inactivation constant of -0.0172 J-¹·cm². Notably, substantial killing was achieved at fluences >100 J·cm-², with LD37and LD90 values of 57.9 and 134.2 J.cm-², respectively.
Cytocompatibility with PBMCs
Mononuclear cells- including circulating lymphocytes, monocytes, and their subsets such as Th1, Th2, Th17, Tregs, and M1/M2 macrophages are key immune cells that produce cytokines upon activation in tissues. These small signaling proteins serve as critical messengers in immune defense, directing responses toward either inflammation or tissue repair depending on the local cytokine environment [17].
So, it is equally important to the demonstration that these bactericidal effects occurred via blue light therapy is without detectable cytotoxicity in PBMCs. Previous studies have shown that under controlled conditions, blue light phototherapy exerts minimal damage to mammalian cells, and our findings corroborate this, as PBMCs retained morphology and proliferative ability across all exposure durations along with maintaining the viability [18-23]. Previous works and other related studies have found that blue light irradiation can induce an increase in intracellular reactive oxygen species (ROS) levels without affecting cell viability [24,25]. This selective antimicrobial pressure reinforces the translational potential of the standardized 30-minute protocol established here.
Blue light exposure of PBMCs at 450 nm does not induce cytokine production, a finding that aligns with prior mechanistic, in vitro, and clinical research across immune and photo biomodulation (PBM) contexts [26-28].
Our observations align with accumulating evidence that blue light does not act as an immunostimulatory signal in resting immune cells. Phan et al. (2016) demonstrated that while blue light increased T-cell motility via a hydrogen peroxide/Lck/PLC-γ1/Ca2+ pathway, this photokinetic effect did not translate into cytokine secretion. Even though intracellular Ca²+ elevations are typically associated with T-cell activation, the absence of co-stimulatory or antigenic signals meant that cytokine gene expression was not initiated. Thus, in the absence of antigen stimulation, as in the present PBMCmodel, blue light exposure alone would not be expected to drive cytokine production. Furthermore, the modest H2O2 generation induced by blue light is insufficient to reach transcriptional thresholds for major cytokines [27]. These mechanistic findings are consistent with clinical data distinguishing local from systemic immune effects. In the AD-Blue randomized trial, Buhl et al. (2023) reported that repeated full-body irradiation with 415 or 450 nm blue light did not alter serum cytokine profiles or PBMC ELISpot responses. Only a local effect was observed in skin, where IL-31 expression was reduced, without systemic immune activation. Importantly, the therapeutic reduction in pruritus occurred without triggering cytokine cascades, indicating that blue light photo biomodulation (PBM) acts locally and remains immunologically safe by avoiding systemic cytokine induction [28].
The dependence on wavelength and spectrum further explains these outcomes. Salmeri et al. (2020) showed that irradiation of human PBMCs with broad-band polarized incoherent light (PILER, 400-2000 nm) suppressed pro-inflammatory cytokines (IL-12p70, IL-17A, IFN-γ, TNF-α) while enhancing regulatory mediators (IL-10, TGF-β1) [17]. By contrast, monochromatic 450 nm blue light did not elicit cytokine production in unstimulated PBMCs, underscoring that broader or higher energy spectra may be necessary to engage multiple photoreceptors and signaling pathways.
In conclusion, our findings that blue light did not induce cytokine release in PBMCs are consistent with prior mechanistic, clinical, and spectral evidence. Blue light phototherapy at 450 nm demonstrates excellent cytocompatibility, preserving PBMC viability and morphology without triggering pro-inflammatory or regulatory cytokine responses. Its selective antimicrobial effect, coupled with minimal oxidative stress insufficient to activate transcriptional cytokine pathways, underscores its safety and translational promise as a disinfection strategy. Future investigations should explore longer exposure protocols, combinatorial light regimens, and in vivo immune dynamics to further define the immunological boundaries and therapeutic potential of blue light.
Mechanistic Basis
A key advantage of blue light therapy is its multifactorial mode of action. Unlike conventional antibiotics that target specific molecular pathways, ROS-mediated damage affects multiple cellular components simultaneously, making it difficult for bacteria to mount stable resistance [18,19]. This may account for the consistent and reproducible reductions we observed across independent experiments. Moreover, the plateau in optical density reduction after shorter exposures (10-25 minutes), followed by a significant additional decline at 30 minutes, reflects the time-dependent kinetics of ROS accumulation, where sustained irradiation is necessary to achieve maximal oxidative stress and biofilm disruption [19,29].
Mechanistically, the observed effects are consistent with established phototherapy principles. Blue light excites endogenous bacterial chromophores such as porphyrins and flavins, leading tothe production of reactive oxygen species (ROS) [20,30]. ROS then induce oxidative damage to bacterial membranes, proteins, and DNA, while also diffusing into the extracellular polymeric matrix, weakening its integrity and reducing bacterial adherence [29]. The significant decline in biomass at 30 minutes reflects the time-dependent kinetics of ROS accumulation, where sufficient exposure duration is necessary to generate lethal oxidative stress levels
Notably, unlike many previous phototherapy or photodynamic therapy studies that require exogenous photosensitizers to enhance ROS generation, the present work demonstrates significant anti¬microbial efficacy using blue light alone [26]. This photosensitizer-free approach not only simplifies the protocol but also enhances its translational potential by avoiding the additional complexity, cost, and potential cytotoxicity associated with chemical sensitizers. The findings thus highlight that endogenous bacterial chromophores are sufficient to mediate effective ROS generation and biofilm disruption, underscoring the feasibility of this method as a straightforward yet powerful antimicrobial strategy.
Standardization and Translational Implications
Together, these findings establish a reproducible and statistically validated phototherapy protocol against V. parvula. Thirty minutes of 450 nm LED exposure consistently produced the maximal reduction in biofilm biomass and planktonic CFUs while maintaining host cell viability. Along with strong statistical support (ANOVA, Kruskal–Wallis, and Tukey’s HSD all yielding significant results), these results lend confidence to defining this condition as the optimized therapeutic window. Unlike prior studies where irradiation times varied widely (5-45 minutes) due to the lack of standardized protocols, our results provide a clear benchmark by validating 30 minutes as the most effective and safe exposure duration [31]. This standardization reduces variability across experiments and advances blue light phototherapy toward reproducible and clinically translatable applications.
By integrating quantitative biomass assays, CFU enumeration, microscopic validation, advanced statistical testing, and cytocompatibility assessments, this study provides a comprehensive evidence base for blue light phototherapy as a clinically relevant antimicrobial strategy.The mechanistic insights into ROS-mediated bacterial killing, coupled with the demonstrated absence of mammalian cytotoxicity, enhance the translational value of the approach. Importantly, the dual action against biofilm and planktonic forms of V. parvula addresses a critical clinical challenge where conventional antibiotics often fail.
This standardized protocol not only strengthens the disinfection potential of blue light but also positions it as a strong candidate for further clinical development as an adjunct or alternative strategy for managing V. parvula infections. However, future research should extend beyond in vitro validation to include in vivo studies, where host-pathogen interactions, tissue penetration, and immune responses may influence treatment efficacy. Moreover, testing this protocol against a broader panel of multidrug-resistant pathogens-including both Gram-negative and Gram-positive species will be essential to confirm its wider antimicrobial spectrum and clinical applicability. Importantly, combinatorial strategies should also be explored, as phototherapy may act synergistically with conventional antibiotics or bacteriophage therapy, enhancing bacterial clearance and minimizing the likelihood of resistance development. Such integrative approaches could accelerate the translation of phototherapy into a robust, multi-pronged strategy for managing infections caused by multidrug-resistant organisms
Conclusion
This study demonstrates that 450 nanometer blue-light phototherapy effectively inhibits Veillonella parvula in both biofilm and planktonic forms, producing significant, time and fluence-dependent reductions in microbial biomass and viability. Thirty minutes of exposure was identified as the optimized disinfection window, achieving maximal antimicrobial effect without compromising human peripheral blood mononuclear cell viability or inducing cytokine production. The mechanism relies on endogenous bacterial chromophores generating reactive oxygen species, obviating the need for chemical photosensitizers and minimizing potential cytotoxicity. These findings highlight blue-light phototherapy as a safe, reproducible, and non-chemical strategy for disinfecting removable dental prostheses and appliances, with translational potential for broader antimicrobial applications. Future studies should investigate its efficacy against diverse oral pathogens, multidrug-resistant species, and in in vivo settings to further validate clinical applicability.
References
- Nath, G., & Shukla, A. (2025). Revolutionizing Dentistry with Molecular Diagnostics.
- Siripaisanprasert, K., Prapinjumrune, C., & Changsiripun,C. (2025). Oral Candida in Orthodontic Patients Wearing Removable Orthodontic Appliances: A Systematic Review and Meta-Analysis. International Dental Journal, 75(5), 100905.
- Ercalik-Yalcinkaya, S., & Özcan, M. (2015). Association between oral mucosal lesions and hygiene habits in a population of removable prosthesis wearers. Journal of Prosthodontics, 24(4), 271-278.
- Lee, Y. H., Chung, S. W., Auh, Q. S., Hong, S. J., Lee, Y. A.,Jung, J., ... & Hong, J. Y. (2021). Progress in oral microbiome related to oral and systemic diseases: an update. Diagnostics, 11(7), 1283.
- Procópio, A. L. F., Da Silva, R. A., Maciel, J. G., Sugio, C.Y. C., Soares, S., Urban, V. M., & Neppelenbroek, K. H. (2018). Antimicrobial and cytotoxic effects of denture base acrylic resin impregnated with cleaning agents after long-term immersion. Toxicology in Vitro, 52, 8-13.
- Kumar, S., & Saran, R. (2024). Preserving Integrity: Investigating the Influence of Disinfecting Agents on Polymethylmethacrylate Dental Prosthesis Surface Characteristics in Children. International Journal of Clinical Pediatric Dentistry, 17(12), 1404.
- Kiesow, A., Sarembe, S., Pizzey, R. L., Axe, A. S., & Bradshaw,D. J. (2016). Material compatibility and antimicrobial activity of consumer products commonly used to clean dentures. The Journal of prosthetic dentistry, 115(2), 189-198.
- Axe, A.S., Varghese, R., Bosma, M., Kitson, N., & Bradshaw,D.J. (2016). Dental health professional recommendation and consumer habits in denture cleansing. The Journal of Prosthetic Dentistry, 115(2), 183–188.
- Luchian, I., Budalá, D. G., Baciu, E. R., Ursu, R. G., Diaconu-Popa, D., Butnaru, O., & Tatarciuc, M. (2023). The involvement of photobiology in contemporary dentistry—A narrative review. International Journal of Molecular Sciences, 24(4), 3985.
- Abdelaziz, A. A., Doghish, A. S., Salah, A. N., Mansour, R. M., Moustafa, Y. M., Mageed, S. S. A., ... & Doghish, Y. A. (2025). When oral health affects overall health: biofilms, dental infections, and emerging antimicrobial strategies. Infection, 1-22.
- Zhou, P., Manoil, D., Belibasakis, G. N., & Kotsakis, G. A. (2021). Veillonellae: beyond bridging species in oral biofilm ecology. Frontiers in Oral Health, 2, 774115.
- Zheng, J. X., Lin, Z. W., Chen, C., Chen, Z., Lin, F. J., Wu,Y., ... & Deng, Q. W. (2018). Biofilm formation in Klebsiella pneumoniae bacteremia strains was found to be associated with CC23 and the presence of wcaG. Frontiers in cellular and infection microbiology, 8, 21.
- O'Toole, G. A. (2011). Microtiter dish biofilm formation assay. Journal of visualized experiments: JoVE, (47), 2437.
- Kleiveland, C. R. (2015). Peripheral blood mononuclear cells. The Impact of Food Bioactives on Health: in vitro and ex vivo models, 161-167.
- Strober, W. (1997). Trypan blue exclusion test of cell viability.Current protocols in immunology, 21(1), A-3B.
- Mashima, I., & Nakazawa, F. (2014). The influence of oral Veillonella species on biofilms formed by Streptococcus species. Anaerobe, 28, 54-61.
- Salmeri, F. M., Denaro, L., Ruello, E., Acri, G., Gurgone, S., Sansotta, C., & Testagrossa, B. (2020). Irradiation with polychromatic incoherent low energy radiation of human peripheral blood mononuclear cells in vitro: Effects on cytokine production. International Journal of Environmental Research and Public Health, 17(4), 1233.
- Huo, J., Jia, Q., Huang, H., Zhang, J., Li, P., Dong, X., & Huang, W. (2021). Emerging photothermal-derived multimodal synergistic therapy in combating bacterial infections. Chemical Society Reviews, 50(15), 8762-8789.
- Lu, M., Li, S., Liu, Y., Xu, B., Liu, S., Zhang, J., ... & Liu,H. (2024). Advances in phototherapy for infectious diseases.Nano Today, 57, 102327.
- Castano, A. P., Demidova, T. N., & Hamblin, M. R. (2004). Mechanisms in photodynamic therapy: part one— photosensitizers, photochemistry and cellular localization. Photodiagnosis and photodynamic therapy, 1(4), 279-293.
- Tian, Q., Yang, Y., Li, A., Chen, Y., Li, Y., Sun, L., ... & Zhang,L. (2021). Ferrihydrite nanoparticles as the photosensitizer augment microbial infected wound healing with blue light. Nanoscale, 13(45), 19123-19132
